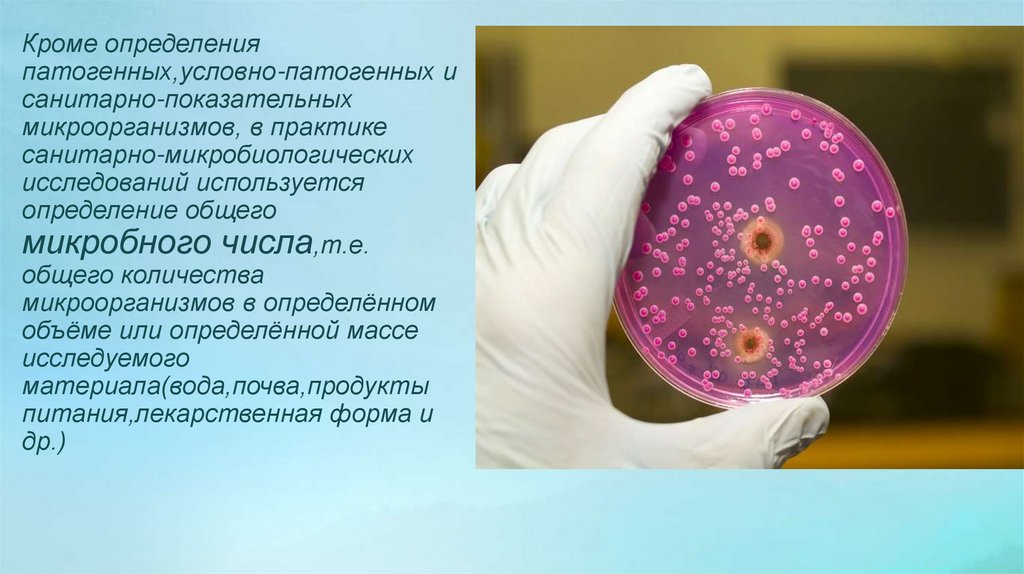

Similar presentations:
Бактериологический метод исследования микроорганизмов. Микрофлора окружающей среды и организма человека
1.
Кафедра микробиологииЗаведующий кафедрой: Базиков Игорь Александрович
2.
ЗАНЯТИЕ № 8БАКТЕРИОЛОГИЧЕСКИЙ МЕТОД
ИССЛЕДОВАНИЯ
МИКРООРГАНИЗМОВ. МИКРОФЛОРА
ОКРУЖАЮЩЕЙ СРЕДЫ И ОРГАНИЗМА
ЧЕЛОВЕКА.
3.
План занятия:Общая цель занятия: научить студентов разбираться в понятиях нормофлоры, условно-патогенной
флоры, патогенной флоры, человека и окружающей среды; отрабатывать навык приготовления мазков
из колоний и посев микроорганизмов, проводить санитарно – бактериологические исследования воды,
воздуха, микрофлоры желудочно-кишечного тракта, применение которых необходимо будущим
специалистам в рамках обязанностей врача.
• А. Обсуждаемые вопросы:
• Изучение микрофлоры окружающей
среды и организма человека, её
практическое значение для медицины.
• Методы определения микрофлоры
полости рта, микрофлоры воды, воздуха в
медицинских и учебных помещениях.
• Нормальная микрофлора тела человека,
количественные и качественные
показатели.
• Санитарно-бактериологические
исследования: полости рта, кожи
человека и содержимого желудочнокишечного тракта, трактование
полученных результатов.
• Б. Практическая работа:
• Санитарно-бактериологическое исследование воды:
• а) определение микробного числа (воды).
• б) определение коли- титра и коли- индекса различных объектов
окружающей среды.
• Санитарно-бактериологические исследования воздуха: посев
воздуха в учебном помещении, учет роста качественный
(приготовление мазков) и количественный (подсчет колоний).
• Санитарно-бактериологические исследования микрофлоры
организма человека:
• а) микрофлоры кожи: посев отпечатков пальцев на МПА в чашки
Петри с последующим макроскопическим и микроскопическим
изучением выросших колоний;
• б) микрофлоры полости рта:
• микроскопия мазка из зубного налета, посев слизи из зева
методом «кашлевых пластинок» и микроскопическое изучение
выросших колоний.
• в) микрофлоры желудочно-кишечного тракта: посев спражнений на
МПА и среду Эндо и микроскопический учет выросших колоний.
• 4. а) Учет действия света на рост микроорганизмов (опыт
Бухнера).
• б) Знакомство с пигментообразующими культурами.
•В. Вопросы для самоподготовки:
•а) Нормальная микрофлора воды и почвы и их
роль в процессах самоочищения окружающей
среды.
•б) Понятие о санитарно-показательных
микробах окружающей среды и организма
человека.
•в) Правила и методы отбора проб воды и
воздуха, определение микробного числа, коли
— титра, коли- индекса, количества
микроорганизмов в 1 м3 воздуха и их
санитарно-эпидемиологическое значение.
•г) Понятие о нормальной микрофлоре
организма человека, её количественная и
качественная характеристика и значение для
организма (витаминообразующее,
ферментативное и активизирующее иммунную
систему).
•д) Гнотобиология – понятие и значение этого
раздела медицины
4.
А.Обсуждаемые вопросыИзучение микрофлоры окружающей среды и организма человека, её
практическое значение для медицины.
Взаимоотношения микроорганизмов между собой и с
окружающей средой изучает экология (греч. oikos –
жилище, logos – понятие, учение).
Этот термин предложил в 1866 году Э. Геккель.
Экология микроорганизмов исследует лишь
отдельные части целостных экологических систем.
Основной единицей в экологии является экосистема. В
нее входят как биологические,
так и абиотические компоненты. Биотические
компоненты составляют
сообщество организмов, или биоценоз. Под
абиотическими компонентами
следует понимать физические и химические условия
экосистемы, в которой живут организмы. Размеры
микробных экосистем очень разнообразны. Это может
быть, например, пруд, озеро или корневая система
дерева. Возможны
и такие маленькие экосистемы, как ротовая полость
или участок кишечника.
В пределах экосистемы для каждого вида можно
описать его место обитания.
5.
Санитарная микробиология — направлениемедицинской микробиологии, изучающее микрофлору
окружающей среды и её влияние на здоровье человека и
состояние среды его обитания. Началом развития
санитарной микробиологии можно считать 1883 г.,
когда французский врач Э. Масе предложил
рассматривать кишечную палочку как показатель
фекального загрязнения воды. Санитарная
микробиология разрабатывает методы контроля за
состоянием воды, почвы, воздуха, пищевых продуктов и
различных предметов обихода. Основные задачи
санитарной микробиологии:
1) Изучение биоценозов, в которых существуют
микробы, патогенные для человека, и изучение его роли
в их накоплении.
2) Разработка методов микробиологических
исследований внешней среды, микробиологических
нормативов и мероприятий по оздоровлению объектов
окружающей среды.
6.
Обнаружение патогенных микроорганизмов позволяет дать оценкуэпидемиологической ситуации и принять соответствующие меры
по борьбе и профилактике инфекционных заболеваний. Патогенные
микроорганизмы попадают в почву, воду, воздух, на пищевые
продукты из выделений больных людей и животных, а также
выделений бактерио- и вирусоносителей.
Непосредственно обнаружить патогенные микробы в объектах
внешней среды чрезвычайно трудно ввиду их малой концентрации.
Кроме того, их наличие, как правило, не удается зафиксировать в
межэпизоотический и межэпидемический периоды. Выявлению
патогенных микроорганизмов препятствуют также сапрофитные
микроорганизмы, обитающие во внешней среде в большом
количестве.
Поэтому делались попытки найти косвенные показатели
загрязнения внешней среды патогенными микроорганизмами. Для
этих целей оказалось возможным использовать микроорганизмы,
постоянно обитающие в организме человека и животных (толстом
отделе кишечника и верхнем отделе дыхательных путей). Такие
микроорганизмы были названы санитарно-показательними. В
основном они являются комменсалами и только при изменении
условий проявляют условно-патогенные свойства.
7.
Санитарно-показательные микроорганизмы должныудовлетворять следующим требованиям:
- постоянно обитать в естественных полостях организма
человека или животного и в большом количестве выделяться во
внешнюю среду;
- продолжительность выживания во внешней среде санитарнопоказательных микроорганизмов должна быть такой же или
несколько большей, чем соответствующих патогенных микробов;
- быть более устойчивыми к воздействию физических и химических
факторов внешней среды, чем патогенные микроорганизмы;
- не должны размножаться во внешней среде;
- должны легко выделяться из объектов внешней среды, не
подавляться сапрофитами;
- при попадании во внешнюю среду не должны быстро изменять
свои биологические свойства.
Из постоянных обитателей толстого отдела кишечника в
качестве санитарно-показательных микроорганизмов приняты
следующие: бактерии группы кишечных палочек, энтерококки,
сульфитредуцирующие анаэробы (преимущественно Cl.
perfringens), бактерии рода Proteus, кишечные бактериофаги; из
постоянных обитателей слизистых оболочек верхнего отдела
дыхательных путей стрептококки (зеленящий стрептококк
Streptococcus viridans и гемолитический стрептококк Streptococcus
haemolyticus); стафилококки гноеродный, или золотистый
Staphylococcus pyogenes (aureus).
8.
Кроме определенияпатогенных,условно-патогенных и
санитарно-показательных
микроорганизмов, в практике
санитарно-микробиологических
исследований используется
определение общего
микробного числа,т.е.
общего количества
микроорганизмов в определённом
объёме или определённой массе
исследуемого
материала(вода,почва,продукты
питания,лекарственная форма и
др.)
9.
Методы определения микрофлоры полости рта.При определении микрофлоры полости рта в
настоящее время применяется целый ряд классических
методов. Так, для изучения качественного состава
микрофлоры идентифицируют микроколонии и/или
микробные тела при микроскопии. Количественную
оценку микрофлоры проводят путем посева на
селективные и неселективные среды с последующим
подсчетом колоний микроорганизмов.
Вместе с тем за последние полтора столетия были
разработаны и внедрены в лабораторную практику
десятки новых методов изучения микрофлоры, такие
как проточная цитометрия, серологические
исследования, анализ белков, сравнение ДНКпоследовательностей и др. Однако многие из этих
методов требуют приготовления бактериальных
культур, что радикально удлиняет время анализа
(например, проточная цитометрия), к тому же после
культивирования невозможно определить начальную
концентрацию микроорганизма в образце, соотношение
погибших и живых клеток.
10.
Методы определения микрофлоры воды.Загрязненность воды определяется по общей микробной
обсемененности и обнаружению санитарно-показательных
микроорганизмов — индикаторов наличия выделений человека
или животных. В воде регистрируют кишечную палочку, БГКП
(колиформные палочки), энтерококк, стафилококки;
На основании количественного выявления этих санитарнопоказательных бактерий вычисляются индекс БГКП (число
БГКП в 1 л воды), перфрингенс-титр, титр энтерококка и т.д.
К бактериям группы кишечной палочки относят
грамотрицательные палочки, сбраживающие с образованием
кислоты и газа лактозу или глюкозу при температуре 37°С в
течение 24-48 ч и не обладающие оксидазной активностью.
Наиболее часто этот показатель применяют как индикатор
фекального загрязнения воды. Другой сходный показатель
фекального загрязнения — общие колиформные бактерии:
грамотрицательные, оксидаза-отрицательные палочки,
ферментирующие лактозу или маннит (глюкозу) с
образованием альдегида, кислоты и газа при температуре 37°С
в течение 24 часов. Вместо последнего термина предлагается
использовать термин «бактерии семейства
Enterobacteriaceae», так как все бактерии этого семейства
имеют индикаторное значение. К бактериям семейства
Enterobacteriaceae относятся грамотрицательные,
оксидазаотрицательные палочки, растущие на
лактозосодержащих средах типа среды Эндо и
ферментирующие глюкозу до кислоты и газа при температуре
37°С в течение 24 часов; колиформные бактерии (палочки).
11.
При бактериальном загрязнении воды свыше допустимых норм следуетпровести дополнительное исследование на наличие бактерий — показателей
свежего фекального загрязнения. К таким бактериям относят
термотолерантные колиформные бактерии, фекальные кишечные палочки,
ферментирующие лактозу до кислоты и газа при температуре 44 °С в
течение 24 часов и не растущие на нитратной среде. О свежем фекальном
загрязнении свидетельствует также выявление энтерококка. На давнее
фекальное загрязнение указывают отсутствие БГКП и наличие определенного
количества клостридий перфрингенс, т. е. наиболее устойчивых
спорообразующих бактерий.
В соответствии с нормативными документами регламентируются следующие
нормативы микробиологических показателей питьевой воды при
централизованном водоснабжении:
1. Общее микробное число воды не должно превышать 100 микробов в 1 мл исследуемой воды;
2. Общие колиформные бактерии должны отсутствовать в 100 мл исследуемой воды;
3. Термотолерантные колиформные бактерии должны отсутствовать в 100 мл исследуемой воды;
4. Колифаги не должны определяться в 100 мл исследуемой воды (учет по бляшкообразующим единицам);
5. Споры сульфитредуцирующих клостридий не должны определяться в 20 мл
исследуемой воды;
6. Цисты лямблий не должны определяться в 50 мл исследуемой воды.
Кроме того, загрязненность воды оценивается по обнаружению патогенных
микробов с фекально-оральным механизмом передачи (энтеровирусы,
энтеробактерии, холерные вибрионы и др.).
12.
Методы определения микрофлоры воздуха в медицинских иучебных помещениях.
Воздух – неблагоприятная среда для
микроорганизмов. Он не является средой
постоянного обитания, а только
временного нахождения или переноса
микроорганизмов. В воздухе нет
питательных веществ, постоянной
оптимальной температуры, часто
отсутствует влага, губительно
действуют на микробы солнечные лучи.
Микроорганизмы попадают в воздух
главным образом с пылью или каплями
жидкости с поверхности почвы, растений,
животных, транспорта, водной
поверхности. Микробиологический
контроль воздуха проводится с помощью
методов естественной или
принудительной седиментации микробов.
13.
Естественнаяседиментация(по методу
Коха)проводится в течении 510 мин. Путём осаждения
микробов на поверхность
твёрдой питательной среды в
чашке Петри.
Принудительная седиментация микробов
осуществляется путём «посева» проб воздуха на
питательные среды с помощью специальных
приборов(импакторов,импинджеров,фильтров).Импакто
-ры-приборы для принудительного осаждения микробов
из воздуха на поверхность питательной среды(прибор
Кротова,пробоотборник аэрозоля бактериологический и
др.)Импинджеры-приборы,с помощью которых воздух
проходит через жидкую питательную среду или
изотонический раствор хлорида натрия.
14.
Нормальная микрофлора тела человека, количественные и качественныепоказатели.
Организм взрослого человека населен огромным количеством
разнообразных видов микроорганизмов, живущих на поверхности
тела и в полостях, имеющих естественные сообщения с
окружающей средой. Изучая микробный пейзаж тела здорового
человека, можно условно разделить обнаруживаемые
микроорганизмы на три группы: 1) случайные, транзиторные,
неспособные к Длительному существованию в организме
человека, быстро отмирающие; 2) постоянно живущие,
полезные для человека микробы — обитатели его тела
(способные расщеплять и усваивать питательные вещества,
продуцировать витамины, выступающие как антагонисты
патогёиных, например, бифидобактерии); 3)
постоянноживущие, но потенциально опасные для человека,
способные проявить свои болезнетворные свойства при
снижении резистентности организма, изменении состава
нормальной микрофлоры и других условиях, — так называемые
условно-патогенные микроорганизмы.
Микроорганизм и его микробное население в нормальных
условиях находятся в состоянии динамического равновесия.
Симбиотические взаимоотношения между ними сложились и
закрепились в процессе длительного эволюционного развития,
поэтому для микрофлоры каждой области тела человека
характерно относительное постоянство. Изменения в
состоянии макроорганизма находят отражение в изменении
микробного пейзажа всех участков тела.
15.
Микрофлора кожи человека.На коже,в её более глубоких слоях(волосяных
мешочках,протоках сальных и потовых желёз)анаэробов
в 2-10 раз больше,чем аэробов.Кожу колонизируют
пропионибактерии, коринеформные бактерии,
стафилококки, стрептококки, дрожжи Pityrosporum,
дрожжеподобные грибы Candida, редко микрококки, Мус.
fortuitum. На 1 см2 кожи приходится менее 80000
микроорганизмов. В норме это количество не
увеличивается в результате действия бактерицидных
стерилизующих факторов кожи, в частности в поте
кожи обнаружены а-глобулин, иммуноглобулины A, G,
трансферрин, лизоцим и другие противомикробные
вещества. Процесс самоочищения кожи усиливается на
чисто вымытой коже. Усиленный рост микроорганизмов
происходит на грязной коже; при ослаблении организма
размножающиеся микроорганизмы определяют запах
тела. Через грязные руки происходит контаминация
(загрязнение) лекарственных средств
микроорганизмами кожи, что приводит к последующей
порче лекарственных препаратов.
Микрофлора кожи имеет большое значение в
распространении микроорганизмов в воздухе. В
результате десквамации (шелушения) несколько
миллионов чешуек, несущих каждая по несколько
микроорганизмов, загрязняют окружающую среду.
16.
Микрофлора конъюнктивы глаза, благодарябактерицидному действию лизоцима очень бедна. В
небольшом количестве встречаются Corynebacterium
xerosis, стафилококки.
Микрофлора дыхательных путей. Микроорганизмы,
содержащиеся во вдыхаемом воздухе, большей
частью погибают в полости носа. Постоянными
обитателями здесь являются микрококки,
стафилококки, дифтероиды, нейссерии. Трахея и
бронхи свободны от постоянной микрофлоры.
Полость рта наиболее богата по разнообразию видов
бактерий, грибов, простейших, вирусов. Постоянные
обитатели способны к адгезии - прикреплению к
поверхности зубов или слизистой оболочки. Состав
микрофлоры зависит от состояния организма, от
состава пищи, от гигиены полости рта.
17.
Микрофлора желудочно-кишечного тракта.Микрофлора желудка бедна. Несмотря на то, что несколько раз и день в желудок попадает большое количество
микробов, многие из них погибают под действием желудочного сока. Могут встречаться в небольшом количестве сарцины,
дрожжи. При пониженной кислотности желудочного сока число микробов возрастает.
Микрофлора тонкой кишки
небогата вследствие бактерицидных свойств кишечного секрета.
Микрофлора толстой кишки наиболее обильна по количеству микробов. Состав ее формируется в течение первых
месяцев жизни и зависит от способа вскармливания. Вскоре после рождения у грудных детей, питающихся молоком
матери, формируется стабильная кишечная микрофлора, состоящая, в основном, из анаэробных неспоровых грамположительных Bacterium bifidum и факультативно-анаэробных молочнокислых грамположительных Bacterium acidophilum.
У более старших детей и у взрослых в кишечной микрофлоре также
преобладают анаэробы: грамположительные бифидумбактерии и
грамотрицательные анаэробные бактероиды. На них приходится 9699% всей микрофлоры. От 1 до 4% составляют факультативные
анаэробы - кишечные палочки, энтерококки, лактобактерии; на долю
остаточной микрофлоры - стафилококков, протея, дрожжей,
клостридий -приходится менее 1%.
Микрофлора толстой кишки, в основном, является полезной для
человека. Бактерии, тесно связанные со слизистой оболочкой
благодаря адгезии (главным образом, бифидо- и лактобактерии),
образуют на ее поверхности биологическую пленку,
препятствующую размножению и проникновению патогенных
микробов. Кроме того, микробная флора является антагонистом
гнилостной микрофлоры, а также играет роль в водно-солевом
обмене, в превращении пищеварительных ферментов, в продукции
витаминов.
18.
Микрофлора мочеполовой системы.В нижней части мочеиспускательного канала встречаются бактероиды, коринебактерии, микобактерии, кишечные
палочки. На наружных половых органах обнаруживаются непатогенные трепонемы, которые следует отличать от
возбудителя сифилиса.
Микрофлора влагалища у новорожденных девочек состоит из молочнокислых бактерий, полученных от матери в
момент рождения. У девочек до периода полового созревания микрофлора влагалища непостоянна (в основном, это
кокки) и во многом зависит от гигиенических навыков ребенка.
С наступлением половой зрелости создаются благоприятные условия для развития грамположительной молочнокислой бактерии, так называемой палочки Додерлейна.
Наличие этой палочки препятствует размножению
других микробов. Поэтому следует осторожно
использовать антибактериальные средства, к которым
чувствительны молочнокислые бактерии.
Различают четыре степени чистоты влагалищного
секрета: I степень - реакция среды кислая, в мазке палочки Додерлейна, клетки плоского эпителия; II
степень - реакция близка к нейтральной, в мазке палочки
Додерлейна, клетки плоского эпителия, небольшое
количество других микробов; III степень - реакция
слабощелочная, в мазке палочек Додерлейна мало,
преобладают кокки, много лейкоцитов; IV степень палочек Додерлейна нет, много лейкоцитов, кокков,
палочек. Неблагоприятное действие на микрофлору
влагалища оказывают воспалительные процессы,
аборт, нарушение гормонального состояния (диабет).
Во время беременности гормональная перестройка
способствует нормализации влагалищной микрофлоры,
развитию молочнокислых бактерий, с которыми
встречается новорожденный в процессе родов.
19.
Гнотобиология.Гнотобиология-(греч. gnotos указанный, известный + биология)отрасль экспериментальной биологии и медицины, занимающаяся
получением и выращиванием стерильных животных, а также
животных, микрофлора которых состоит из точно известных
одного или нескольких видов микроорганизмов(гнотофоров), с
целью изучения механизмов и форм взаимодействия микроба с
макроорганизмом. Безмикробных животных получают путем
естественного воспроизведения обычных животных в стерильных
условиях или посредством размножения безмикробных животных,
гнотофоров - путем искусственного заражения безмикробных
животных культурой одного или нескольких точно
идентифицированных видов. Выращивают и содержат
гнотобиотов в специальных изоляторах или помещениях
барьерного типа. Их обеспечивают полноценным стерильным
питанием и подвергают систематическому микробиологическому
контролю. Гнотобиоты обладают высокой восприимчивостью к
инфекционным агентам и чувствительностью к некоторым хим.
препаратам. Их используют для изучения различных вопросов
инфекции, иммунитета, обмена веществ, экологии, в частности
роли нормальных микроорганизмов в существовании высших
животных. В практике их применяют для апробации
фармакологических препаратов (напр., антибиотиков) .Принципы
Г. нашли широкое применение в клинической медицине.

biology
biology








